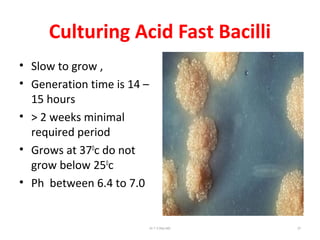
Culturing Acid Fast Bacilli
• Slow to grow ,
• Generation time is 14 –
15 hours
• > 2 weeks minimal
required period
• Grows at 370
c do not
grow below 250
c
• Ph between 6.4 to 7.0
Dr.T.V.Rao MD 27

This document provides information on the history, classification, morphology, culture characteristics, and pathogenesis of Mycobacterium tuberculosis and other mycobacteria. It discusses how tuberculosis spreads through airborne droplets expelled from infected individuals. Key points include:
1) Tuberculosis is caused by Mycobacterium tuberculosis and other members of the M. tuberculosis complex. It has been identified in Egyptian mummies from 1550-1080 BC.
2) Mycobacteria are acid-fast bacilli with a waxy, lipid-rich cell wall. They grow slowly and can survive in sputum and other environments.
3) Tuberculosis spreads when people with active lung TB expel bacteria into the air through